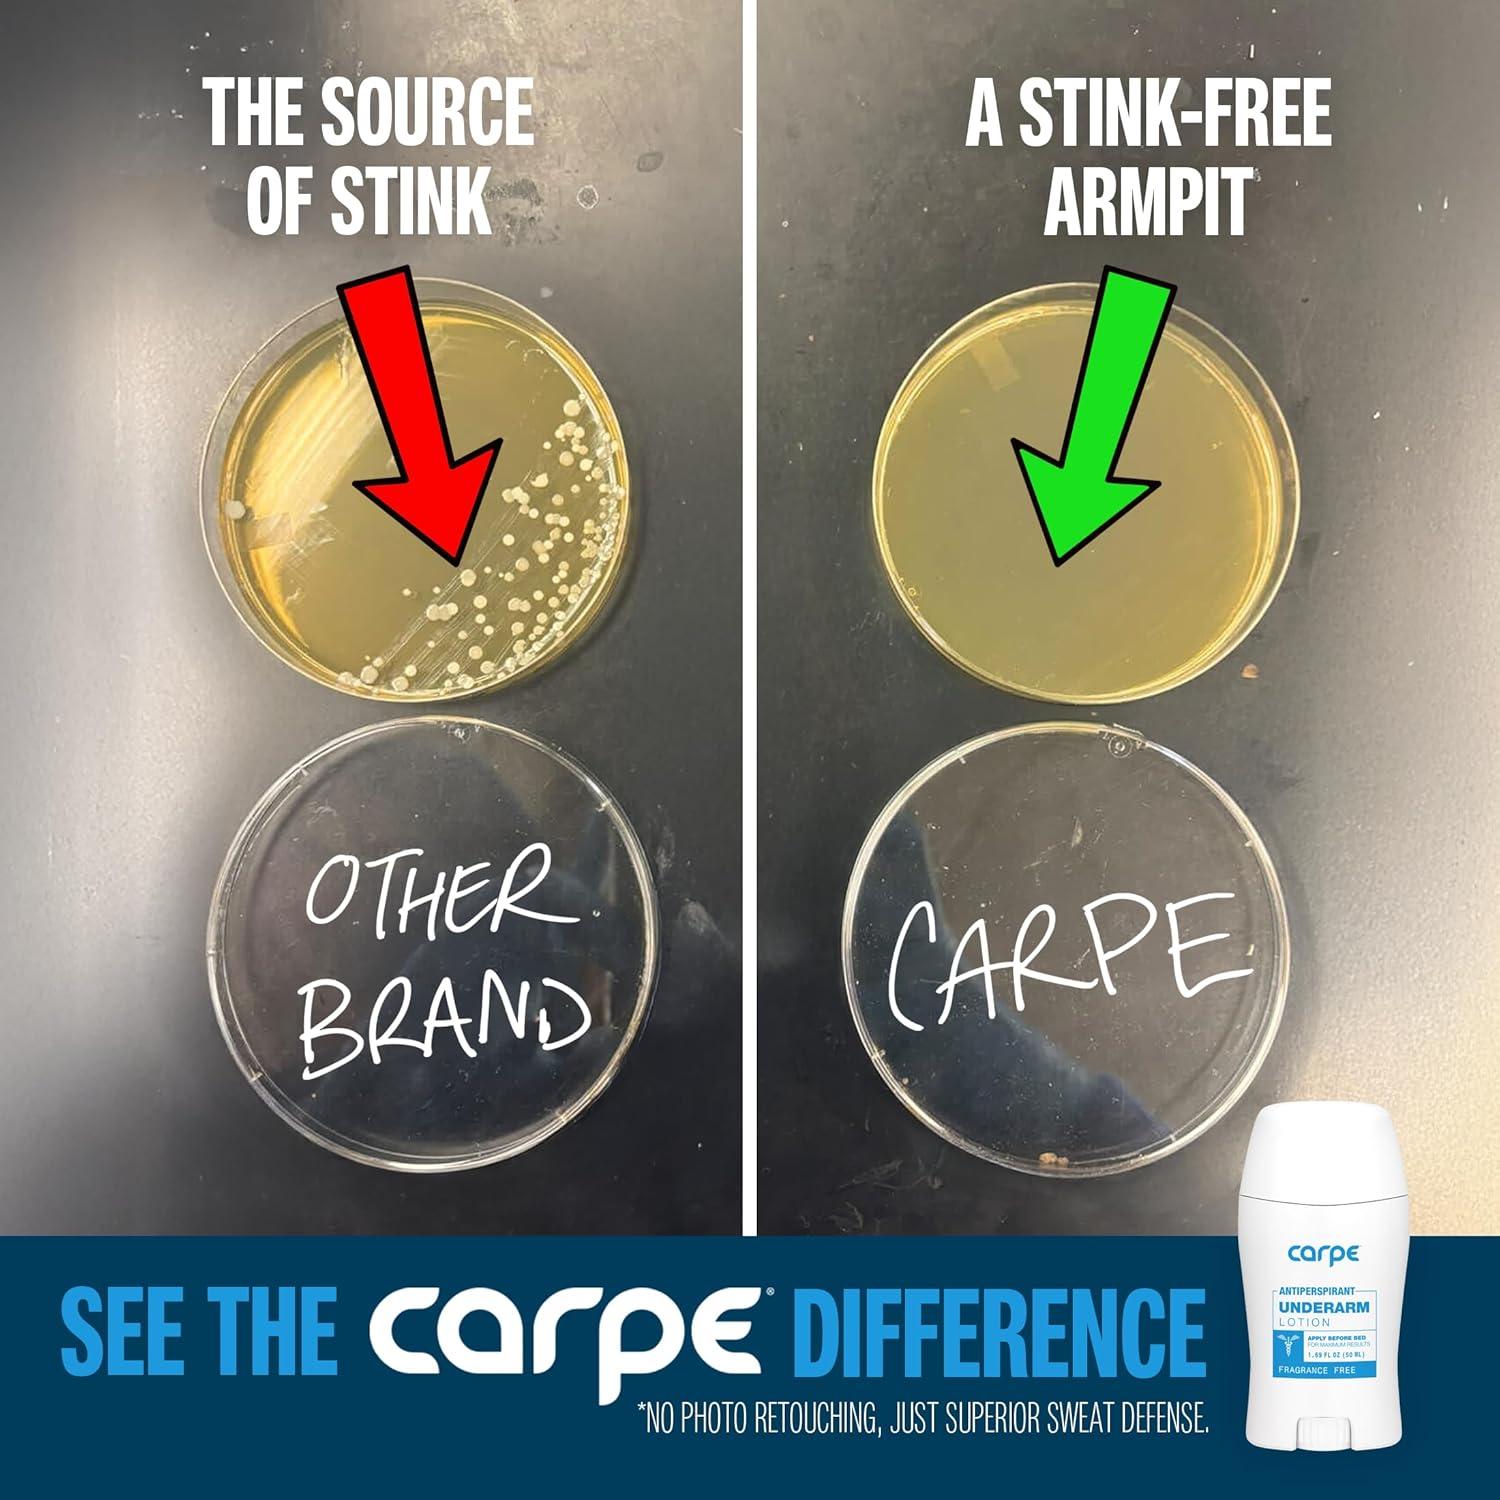

Description
Package Dimensions : 5 x 2.28 x 1.14 inches; 3.84 ounces
UPC : 855769008527
Best Sellers Rank: #8,844 in Beauty & Personal Care (See Top 100 in Beauty & Personal Care)
- #124 in Antiperspirant Deodorant
Customer Reviews:
123 ratings

Reviews
There are no reviews yet.